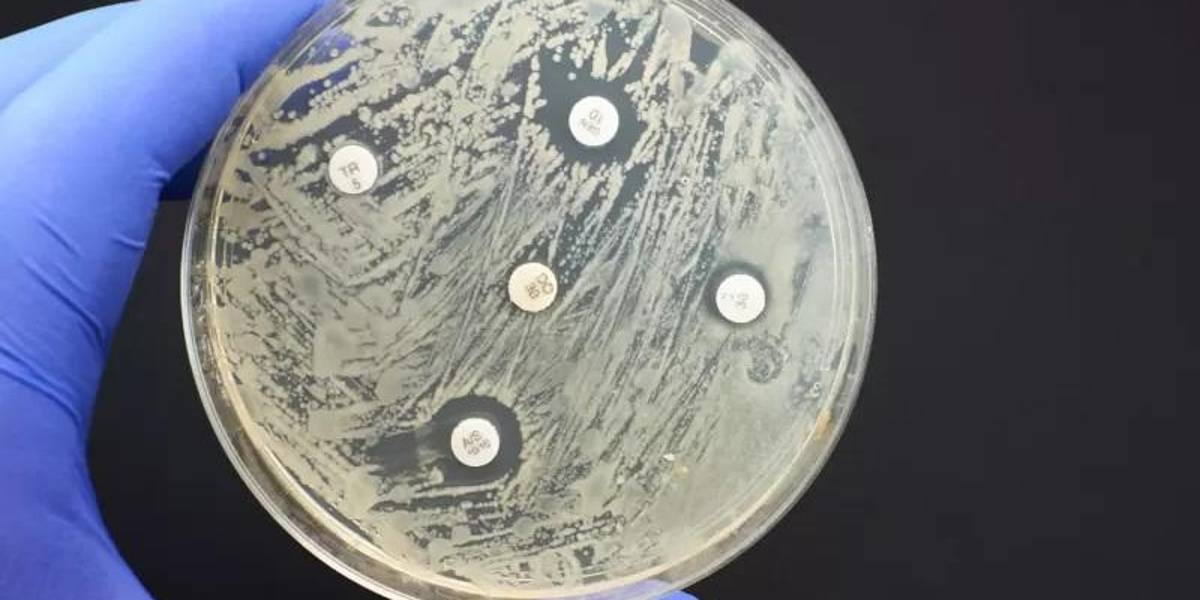

"Pandemia silenciosa": las infecciones por bacterias resistentes a antibióticos matan más personas que la malaria y el sida
Más de 1,2 millones de personas murieron en todo el mundo en 2019 por esta razón.
-
 La resistencia a medicamentos antimicrobianos es una amenaza para la salud a nivel mundial.( )
La resistencia a medicamentos antimicrobianos es una amenaza para la salud a nivel mundial.( )

Más de 1,2 millones de personas murieron en todo el mundo en 2019 como consecuencia directa de infecciones causadas por bacterias resistentes a los antibióticos, según el mayor estudio sobre este tema hasta la fecha.
Esta cifra equivale a un promedio de casi 3.500 fallecimientos cada día.
Los países más pobres son los más afectados, pero la resistencia a los medicamentos antimicrobianos es una amenaza para la salud global, incluyendo América Latina, según el informe.
Además de los 1,2 millones de muertes causadas directamente por bacterias resistentes a antibióticos, el informe calculó que esa resistencia jugó algún papel en enfermedades responsables de otros casi cinco millones de fallecimientos en 2019.
Un estudio referente en el tema de 2014 estimó que la resistencia a los antimicrobianos (RAM) llegaría a causar 10 millones de muertes anuales en 2050, le explicó a BBC Mundo la científica mexicana Gisela Robles Aguilar, investigadora en carga global de enfermedad y resistencia a los antimicrobianos en el Big Data Institute de la Universidad de Oxford en Reino Unido, y una de las autoras del estudio.
Saltar Quizás también te interese y continuar leyendo
Quizás también te interese



Covid: cómo actúa ómicron y cómo defendernos de esta nueva variante

La carrera por entender la misteriosa "amnesia inmunológica" causada por el sarampión
Final de Quizás también te interese
"Ahora sabemos que estamos mucho más cerca de alcanzar esa cifra de lo que pensábamos, pues en 2019 estimamos que 4,95 millones de muertes estuvieron relacionadas con la RAM".
En el mismo año, se calcula que el sida (síndrome de inmunodeficiencia adquirida) causó a nivel global 860.000 muertes y la malaria 640.000.
Los autores del estudio aseguran que es necesario invertir en forma urgente en nuevos medicamentos y usar de forma más responsable los que ya existen.
El uso excesivo de antibióticos para infecciones menores en los últimos años llevó a que se vuelvan menos efectivos contra infecciones graves.
Las personas están muriendo a causa de infecciones comunes que antes eran tratables porque las bacterias que las causan se han vuelto resistentes al tratamiento.
Los niños, los más vulnerables
La estimación de muertes globales por infecciones bacterianas resistentes se basó en un análisis de 204 países realizado por un equipo internacional de investigadores dirigido por la Universidad de Washington en Estados Unidos.
El estudio fue publicado en la revista médica The Lancet.

FUENTE DE LA IMAGEN,GETTY IMAGES
Pie de foto,
Una de cada cinco muertes relacionadas con bacterias resistentes a antibióticos se registró entre menores de cinco años.
La mayoría de las muertes por bacterias resistentes se debió a infecciones de las vías respiratorias inferiores, como neumonía, y a infecciones en la sangre, que pueden causar sepsis.
La bacteria Staphylococcus aureus resistente a la meticilina, o SARM, fue particularmente mortal, según el estudio.
Esta cepa de la bacteria Staphylococcus aureus se ha vuelto resistente a varios antibióticos, incluyendo la penicilina y la meticilina
Escherichia coli y otras bacterias también fueron vinculadas por el estudio a altos niveles de resistencia a los medicamentos.
Los investigadores afirman que los niños pequeños corren mayor riesgo.
Aproximadamente una de cada cinco muertes relacionadas con la resistencia a antibióticos se registró entre menores de 5 años.
El mayor número de muertes tuvo lugar en África subsahariana y el sur de Asia (24 de cada 100.000 muertes).
La incidencia más baja se dio en países de ingresos altos (13 de cada 100.000 muertes).
En América Latina
Del 1,2 millones de muertes por infecciones causadas por bacterias resistentes, "89.100 ocurrieron en América Latina en 2019", señaló a BBC Mundo Robles Aguilar.
"La mayor cantidad de muertes se registró en la región central de América Latina, conformada por Colombia, Costa Rica, El Salvador, Guatemala, Honduras, México, Nicaragua, Panamá y Venezuela, con 28.300 muertes directamente atribuibles a la RAM, y 109.000 muertes relacionadas con la RAM.
"Los países de la región andina, Bolivia, Ecuador y Perú, enfrentan también el reto de combatir la resistencia a los antimicrobianos, pues 11% de las muertes por infección en esos países fueron ocasionadas por un organismo resistente a los antibióticos", agregó la científica.

FUENTE DE LA IMAGEN,GENTILEZA GISELA ROBLES AGUILAR
Pie de foto,
La científica mexicana Gisela Robles Aguilar, investigadora en resistencia antimicrobiana en la Universidad de Oxford, es una de las autoras del estudio.
En cuanto al tipo de infecciones, la científica señaló que "el organismo responsable del mayor número de muertes en la región fue Escherichia coli, que ocasionó aproximadamente 1 de cada 6 muertes atribuibles a la RAM en la región".
"Este organismo se encuentra comúnmente en el sistema digestivo, pero la exposición incremental a antibióticos contribuye a que desarrolle mecanismos de resistencia. Así, infecciones comunes, como por ejemplo infecciones del sistema urinario, son más difíciles de combatir", explica.
"Otro organismo que se mantiene bajo vigilancia en la región latinoamericana es Staphylococcus aureus, que fue responsable de 15.300 muertes en la región latinoamericana, ocasionando principalmente infecciones sanguíneas adquiridas en los hospitales".
Acción urgente
Para el profesor Chris Murray, investigador del Instituto de Medición y Evaluación de la Salud de la Universidad de Washington y uno de los autores del estudio, los nuevos datos revelan la verdadera escala de la resistencia a los antimicrobianos en todo el mundo.

FUENTE DE LA IMAGEN,GETTY IMAGES
Pie de foto,
Es preciso usar los antibióticos existentes en forma más responsable, e invertir más en llevar nuevos medicamentos al mercado, según los autores del estudio.
También son una señal clara de que se requiere una acción inmediata "si queremos mantenernos un paso adelante en la carrera contra la resistencia antimicrobiana", señaló el experto.
El Dr. Ramanan Laxminarayan, del Centro de Dinámica, Economía y Política de Enfermedades, en Washington DC, afirmó que el gasto global para abordar las infecciones resistentes debe aumentar hasta los niveles observados para otras enfermedades.
"El gasto debe dirigirse a la prevención de infecciones en primer lugar, asegurándose de que los antibióticos existentes se usen de manera adecuada y juiciosa, y a llevar nuevos antibióticos al mercado", apuntó.
Sally Davies, experta en resistencia a antibióticos y exasesora principal de salud del gobierno británico, señaló en el pasado que esa resistencia es una "pandemia silenciosa" de la que el mundo debe ocuparse.
Las acciones urgentes y globales durante la actual pandemia de covid pueden mostrar el camino a seguir.
"Uno de los grandes logros de los últimos dos años es el compromiso de adoptar medidas de prevención y control de infecciones, medidas básicas de higiene y campañas de vacunación. Este tipo de medidas son también necesarias para combatir la creciente resistencia de los organismos a los antibióticos, y es ahora un buen momento para incentivar un compromiso similar por distintos actores sociales", afirmó Gisela Robles Aguilar a BBC Mundo.
"El acceso a información de manera rápida, abierta y transparente ha contribuido a combatir la covid-19 y es esencial para monitorear el incremento en el uso de antibióticos en el sector salud así como en el veterinario y la producción de alimentos", agregó la científica.
"Necesitamos medir constantemente el uso de los antibióticos y la resistencia a estos, a fin de conocer el problema de la resistencia y generar soluciones. Y, desde luego, el uso responsable de los antibióticos es una tarea en la que todos podemos contribuir".
Recomendadas